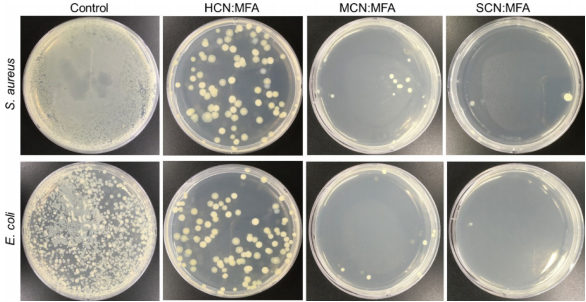

-
生物通官微
陪你抓住生命科技
跳动的脉搏
无聚合物β-环糊精-甲芬那酸包合物纳米纤维的构建及其在增强药物溶解性与生物医学应用中的突破
【字体: 大 中 小 】 时间:2025年08月19日 来源:Scientific Reports 3.9
编辑推荐:
本研究通过无聚合物电纺丝技术构建β-环糊精衍生物(HCN/MCN/SCN)与甲芬那酸(MFA)的包合纳米纤维,显著提升难溶性药物MFA的溶解性(最高达98±0.12 μg/mg),并证实其对大肠杆菌和金黄色葡萄球菌的抗菌效率达99.3±2.89%和98.3±1.69%,在结肠癌细胞HCT-116中显示99.1±1.6%抑制率。该研究为快速溶解给药系统和靶向癌症治疗提供了创新解决方案。
在药物递送领域,难溶性药物的生物利用度提升一直是重大挑战。甲芬那酸(MFA)作为典型的非甾体抗炎药(NSAID),虽具有抗癌潜力,却受限于其水溶性差(40 μg/mg)、治疗剂量高(250-500 mg/次)和胃肠道副作用。传统解决方案往往依赖合成聚合物载体,但存在生物相容性差和环境污染等问题。这一困境促使科学家们探索基于天然环糊精(CDs)的创新递送系统。
来自韩国延世大学(Yonsei University)的研究团队Sonaimuthu Mohandoss等人突破性地采用无聚合物电纺丝技术,将三种β-环糊精衍生物——羟丙基-β-CD(HCN)、甲基-β-CD(MCN)和磺丁基醚-β-CD(SCN)与MFA构建成超分子包合物纳米纤维(NFs)。这项发表在《Scientific Reports》的研究通过相溶解度分析、SEM形貌表征、分子对接等技术,证实该体系能显著改善药物性能,并展现出优异的抗菌抗癌活性。
研究采用的关键技术包括:1)相溶解度分析法测定包合常数;2)无聚合物电纺丝制备纳米纤维;3)紫外光谱和热重分析(TGA)表征药物释放特性;4)菌落计数法评估抗菌活性;5)WST法检测HCT-116结肠癌细胞毒性。
【相溶解度分析】
通过Higuchi-Connors法测得SCN:MFA的稳定常数最高(931.5 M-1),是HCN:MFA(337.1 M-1)的2.8倍,表明磺丁基修饰可显著增强包合作用。溶解度实验显示,原始MFA在水中的溶解度仅40 μg/mg,而SCN:MFA NFs在150秒内释放量达98±0.12 μg/mg。
【形貌特征】

SEM显示所有纳米纤维均呈无串珠结构,其中SCN:MFA直径最小(248±42 nm),比HCN:MFA(675±128 nm)减少63%。小直径伴随更高比表面积,为快速药物释放奠定结构基础。
【功能表征】
FTIR证实MFA的羧基(-COOH)与CDs羟基形成氢键;XRD显示MFA特征结晶峰消失,表明药物完全非晶化;TGA证明包合物热稳定性提升,分解温度从纯MFA的229℃升至SCN:MFA的270℃。
【药物释放】
Higuchi模型拟合显示所有NFs符合Fickian扩散机制(R2>0.99)。SCN:MFA在60秒内释放89±1.7 μg/mg,达HCN:MFA(51±2.1 μg/mg)的1.7倍,这种"秒级"释放特性使其成为口腔速释系统的理想候选。
【抗菌活性】
菌落计数显示SCN:MFA对E. coli和S. aureus抑制率分别达99.3±2.89%和98.3±1.69%,研究者认为磺酸基团的正电荷增强了与细菌膜的静电作用,而纳米纤维的小尺寸促进了活性氧(ROS)生成。
【抗癌效应】

WST实验显示SCN:MFA对HCT-116细胞的IC50低至7.51±2.33 μg/mL,DAPI/PI双染色证实其通过诱导细胞凋亡发挥作用。分子对接揭示SCN的硫原子与癌细胞表面特异性结合,增强靶向性。
该研究开创性地证明:1)无聚合物电纺丝可构建稳定药物-CD包合物;2)磺丁基修饰的β-CD(SCN)在溶解度增强(2.5倍)、抗菌(99.3%抑制)和抗癌(IC50 7.51 μg/mL)三方面均表现最优;3)纳米纤维的快速释放特性突破了传统MFA制剂需多次给药的局限。这些发现不仅为NSAIDs的剂型改造提供新范式,其"天然载体+纳米技术"的策略更为难溶性药物的递送系统设计开辟了新途径。未来研究可进一步探索该体系在口腔黏膜给药和靶向肿瘤治疗中的应用潜力。
生物通微信公众号
知名企业招聘